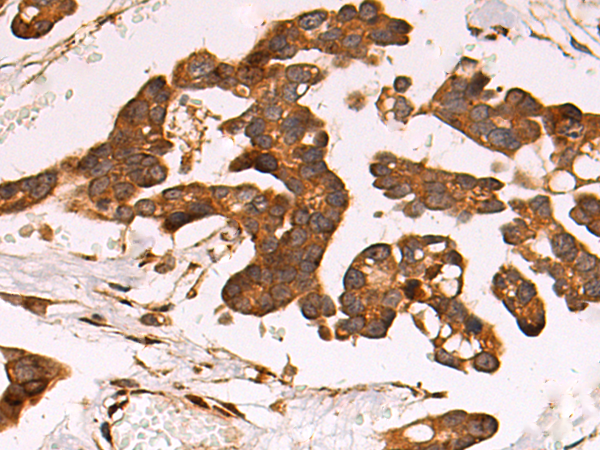
一抗

技術(shù)規(guī)格
Background:
This gene encodes a member of the low-density lipoprotein receptor family of proteins. The encoded preproprotein is proteolytically processed by furin to generate 515 kDa and 85 kDa subunits that form the mature receptor (PMID: 8546712). This receptor is involved in several cellular processes, including intracellular signaling, lipid homeostasis, and clearance of apoptotic cells. In addition, the encoded protein is necessary for the alpha 2-macroglobulin-mediated clearance of secreted amyloid precursor protein and beta-amyloid, the main component of amyloid plaques found in Alzheimer patients. Expression of this gene decreases with age and has been found to be lower than controls in brain tissue from Alzheimer's disease patients.
Applications:
ELISA, WB, IHC
Name of antibody:
LRP1
Immunogen:
Synthetic peptide of human LRP1
Full name:
LDL receptor related protein 1
Synonyms:
APR; KPA; LRP; A2MR; CD91; APOER; LRP1A; TGFBR5; IGFBP3R; IGFBP-3R; IGFBP3R1
SwissProt:
Q07954
ELISA Recommended dilution:
5000-10000
IHC positive control:
Human colorectal cancer and Human tonsil
IHC Recommend dilution:
50-200
WB Predicted band size:
505 kDa
WB Positive control:
Mouse brain tissue, Human cerebrum tissue lysates
WB Recommended dilution:
500-2000



 購物車
購物車 幫助
幫助
 021-54845833/15800441009
021-54845833/15800441009